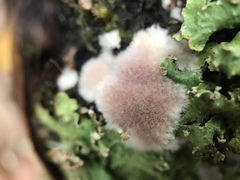
Hypochnella

©Ignacio Torres García, some rights reserved (CC-BY-NC)
©Ignacio Torres García, some rights reserved (CC-BY-NC)
©nataliapaolucci, some rights reserved (CC-BY-NC)
©Alicia Mastretta Yanes, some rights reserved (CC-BY-NC)
©Alison Young, some rights reserved (CC-BY-NC)
©Alison Young, some rights reserved (CC-BY-NC)
©Alison Young, some rights reserved (CC-BY-NC)
©Merav Vonshak, some rights reserved (CC-BY-NC)
©Merav Vonshak, some rights reserved (CC-BY-NC)
©Merav Vonshak, some rights reserved (CC-BY-NC)
©Merav Vonshak, some rights reserved (CC-BY-NC)
©sciencebabe, some rights reserved (CC-BY-NC)
©sciencebabe, some rights reserved (CC-BY-NC)
©sciencebabe, some rights reserved (CC-BY-NC)
©sciencebabe, some rights reserved (CC-BY-NC)
©sciencebabe, some rights reserved (CC-BY-NC)